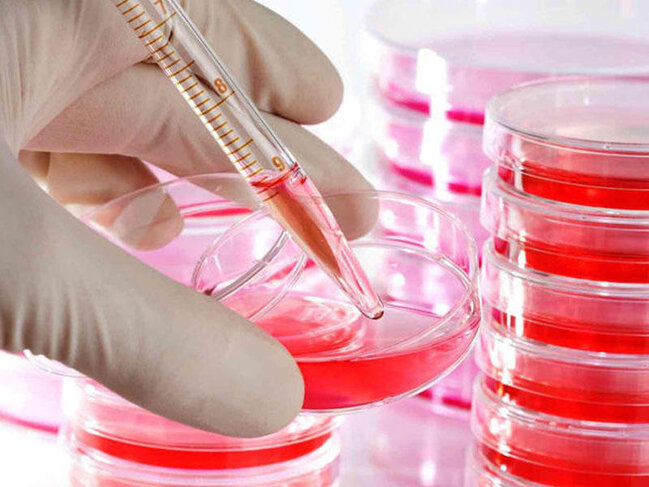
İranda 60 min nəfər QİÇS-ə yoluxub

İranda indiyədək 60 min nəfərin QİÇS virusuna yoluxduğu deyilir.
7News.Az Trend-ə istinadən xəbər verir ki, bunu İranın səhiyyə nazirinin müavini Əlirza Rəisi İranın Səhiyyə Nazirliyində Ümumdünya QİÇS-lə Mübarizə Günü ərəfəsində keçirilən tədbirdə deyib.
Ə.Rəisinin sözlərinə görə, QİÇS virusu müəyyənləşən 40,5 min nəfərin təxminən 18,9 mini dünyasını dəyişib.
Nazir müavini əlavə edib ki, QİÇS virusu müəyyənləşənlərin 82%-i kişi, 18%-i qadındır:
"QİÇS-ə yoluxma hallarının 60%-i şpris, 22%-i cinsi əlaqə, 1,7%-i anadan körpəyə nəql olunmasına aiddir".
Ə.Rəisi əlavə edib ki, ötən il yarım ərzində şprislə yoluxma halı 31% azalıb, cinsi əlaqə ilə yoluxma halı 48,4% artıb.
7News.Az Trend-ə istinadən xəbər verir ki, bunu İranın səhiyyə nazirinin müavini Əlirza Rəisi İranın Səhiyyə Nazirliyində Ümumdünya QİÇS-lə Mübarizə Günü ərəfəsində keçirilən tədbirdə deyib.
Ə.Rəisinin sözlərinə görə, QİÇS virusu müəyyənləşən 40,5 min nəfərin təxminən 18,9 mini dünyasını dəyişib.
Nazir müavini əlavə edib ki, QİÇS virusu müəyyənləşənlərin 82%-i kişi, 18%-i qadındır:
"QİÇS-ə yoluxma hallarının 60%-i şpris, 22%-i cinsi əlaqə, 1,7%-i anadan körpəyə nəql olunmasına aiddir".
Ə.Rəisi əlavə edib ki, ötən il yarım ərzində şprislə yoluxma halı 31% azalıb, cinsi əlaqə ilə yoluxma halı 48,4% artıb.
7News.Az